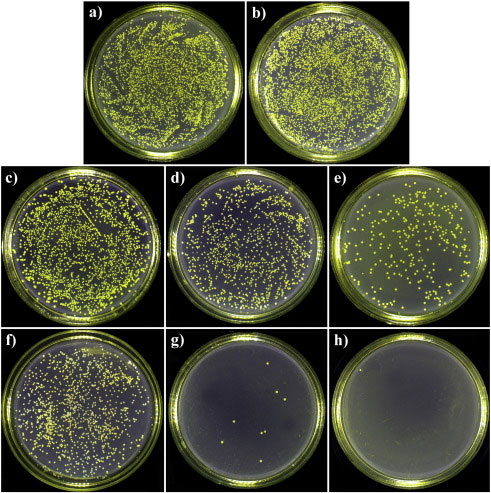
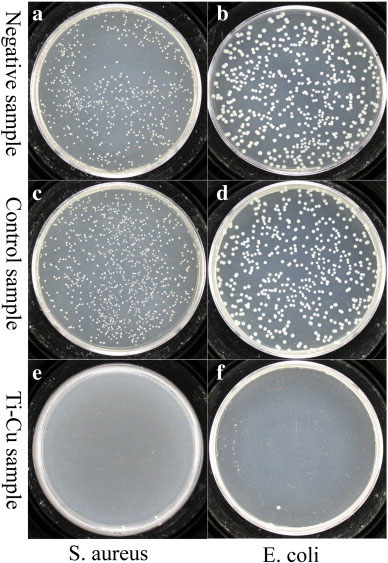
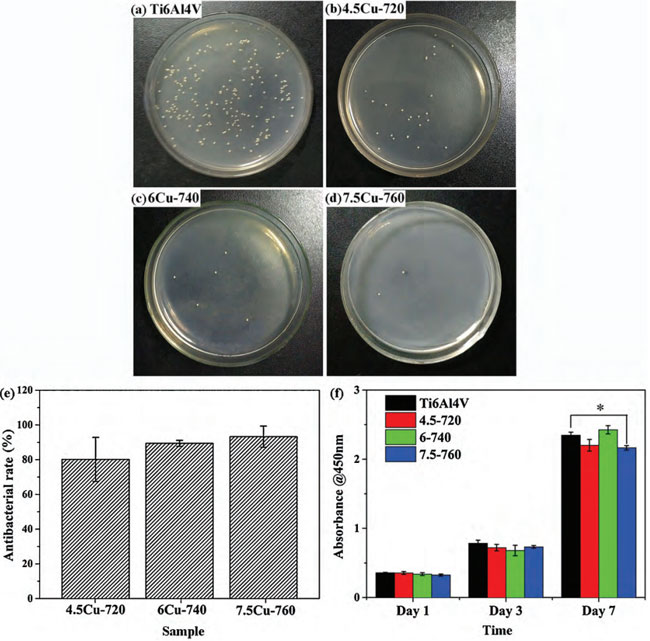

1、引言
鈦(Ti)及其合金具有低密度、高強度、優異耐腐蝕性等特點,最初應用于航空工業。20世紀40年代初,鈦及其合金首次被引入醫學領域。經過半個多世紀的發展,純鈦和Ti6A14V合金作為最具代表性的鈦基醫用金屬材料,在許多醫學臨床中得到應用,特別是在骨科和口腔科領域中大量替代不銹鋼和鈷基合金。然而鈦合金是一類生物惰性材料,自身沒有抗菌性能,對植入物引發的感染問題無能為力。目前通常采用磁控濺射、電化學沉積、離子注入、微弧氧化等方法在醫用鈦合金表面加載無機或有機抗菌劑,從而賦予其抗菌性能。通過表面改性制備的抗菌涂層的優點顯而易見,但仍存在不足,如涂層工藝相對復雜、生產成本增加、涂層與基體之間的結合性差、涂層易磨損、長期的抗菌性能較差等。針對植入鈦合金引發的感染問題和抗菌涂層的不足,人們開始嘗試通過調整合金成分來開發自身具有抗菌功能的新型抗菌鈦合金。
2、抗菌鈦合金的抗菌機理
細菌的傳播與細菌生物膜的形成密切相關,細菌生物膜的形成過程如圖1所示。浮游細菌在材料基體著陸后生長和繁殖,形成細菌生物膜。生物膜表面是一層致密的細胞外基質,這層細胞外基質結構堅固,強度高,內部包裹的細菌接觸緊密,增強了細菌之間的相互作用和物質交換,同時避免外部破壞物質進入。所以生物膜形成后不易受到抗生素、防腐劑及其他外界化學品的干擾,因此很難被常用的抗生素清除掉。

圖1 細菌生物膜的形成過程
抗菌鈦合金的抗菌機理可以分為以下4步:①抗菌金屬表面釋放具有抗菌功能的金屬離子;②帶負電荷的細菌細胞與帶正電的金屬離子之間相互吸引,金屬離子被吸收進細菌的細胞壁;③金屬離子破壞細菌的細胞壁和細胞膜,或破壞其蛋白質結構,使細胞質泄露;④金屬離子進一步穿透細菌的細胞壁,與細菌的DNA結合,導致細菌變性和復制能力的喪失。不論是破壞細胞壁,還是破壞遺傳物質,都會導致細菌死亡。
3、研究進展
3.1 Ti-Ag抗菌鈦合金
銀(Ag)作為合金化元素,可改善鈦基金屬的耐腐蝕性能和力學性能。Takahashi等研究發現,添加20wt%Ag可以提高鑄造鈦合金的強度和耐磨性,同時保持較高的延伸率。Shim等證明Ti-Ag合金具有比純鈦更優的耐腐蝕性能。Ag還具有良好的生物相容性,Ag-Hg合金已被用作牙科材料。含Ag涂層具有優異的抗菌性能已被很多研究所證實,因此,在鈦及其合金中添加合適的Ag,有可能獲得具有一定抗菌性能的含Ag鈦合金。然而,即使有些Ti-Ag合金中的Ag含量非常高,甚至達到20wt%,但其并沒有顯示出顯著的抗菌作用,說明含Ag鈦合金的抗菌作用并不只由Ag含量這一因素所決定。
Zheng等在TiNi形狀記憶合金中加入2.9wt%Ag,獲得的鑄態TiNi合金表現出一定的抗菌性能,對金黃色葡萄球菌的抑菌率達到86.3%。Chen等采用不同含量和不同粒徑的Ag粉和純鈦粉一起燒結,獲得了系列Ti-xAg合金(x=1,3,5),對其力學性能、腐蝕性能、抗菌性能及體外細胞相容性進行了表征和評價。如圖2所示,Ag粉粒徑10μm的Ti-Ag合金的抗菌性高于Ag粉粒徑75μm的Ti-Ag合金,與Ag離子釋放量的規律相反,Ag粉粒徑10μm的Ti-Ag合金的離子釋放量低于Ag粉粒徑75μm的Ti-Ag合金,說明Ti-Ag合金的抗菌性能應與基體上存在的納米/微米級復合銀粒子密切相關。
圖2 純Ti和Ti-Ag合金表面的細菌菌落
3.2 Ti-Cu抗菌鈦合金
2009年,Shirai等首次研究了Ti-xCu(x=1,5)合金的抗菌作用,結果表明Ti-1Cu對大腸桿菌具有顯著的抗菌性能,并具有良好的生物安全性,拉開了含銅鈦合金作為醫用金屬材料研究的帷幕。隨后,Zhang等采用粉末冶金方法制備出Ti-10wt%Cu合金,并對合金的抗菌性能、力學性能和腐蝕性能進行了研究,如圖3所示,Ti-10 Cu合金對金黃色葡萄球菌和大腸桿菌均具有顯著的殺滅作用。對Ti-10Cu合金的骨內植入試驗結果表明,Ti-10Cu合金具有良好的骨細胞相容性。進一步研究結果表明,在鈦中至少加入5%的Cu才會有明顯的抗菌作用。以抗菌抗感染為目的,中國科學院金屬研究所開發出系列具有抗菌功能的含銅鈦合金,并開展了大量的體外及動物體內試驗研究。Cu在Ti中的固溶度很低,從高溫冷卻至790℃時,過飽和的Cu以Ti2Cu金屬間化合物析出,其與基體之間存在的電位差會促進合金在生理環境中釋放微量銅離子,從而起到強烈的殺菌作用。
圖3 Ti-10Cu對黃金葡萄球和大腸桿菌的殺滅效果
3.3 Ti6Al4V-Cu抗菌鈦合金
Peng等對熱加工后的Ti6Al4V-xCu(x=4.5,6,7.5)合金進行了綜合性能優化。研究結果表明,為使合金獲得最佳的力學性能、耐腐蝕性能和耐磨性能,三組合金熱加工后的最佳熱處理工藝分別為在720℃、740℃和760℃保溫1h后空冷,在圖4中分別用4.5Cu-720、6Cu-740和7.5Cu-760表示。三組合金的抗菌試驗和細胞毒性試驗結果如圖4所示,由圖4(a)-(d)可知,與Ti6Al4V合金共培養后的細菌菌落較多,而與Ti6A14V-Cu合金共培養后的細菌菌落數較少,表明含銅鈦合金具有較強的抗菌性能。圖4(e)為Ti6Al4V-xCu合金的抗菌率,可見4.5Cu-720樣品的抗菌率約為80%,隨Cu含量增加,合金的抗菌率略有上升,表明抗菌性能有所提高。由圖4(f)可知,與細胞共培養1天和3天時,Ti6A14V-Cu合金與Ti6A14V合金的吸光度值差別不大;但在7天時,7.5Cu-760的數值顯著低于Ti6A14V合金,表明其在7天時具有一定的細胞毒性。由此可見,對于Ti6A14V-xCu合金,Cu含量應不高于6%,否則在較長時間后,合金會呈現出一定的細胞毒性。
圖4 Ti6A14V (a)4.5Cu-720;(b)6Cu-740;(c)7.5Cu-760;(d)合金共培養后的細菌生長形貌;(e)Ti6Al4V合金的抗菌率對比圖;(f)細胞與不同合金共培養1天、3天和7天后的吸光度值


